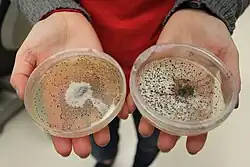

Бактериология
.jpg)
Бактериология — (греч. βακτηρία — бактерия, греч. λόγος — учение)[1] — это раздел микробиологии, изучающий бактерии. Разделяется на несколько самостоятельных направлений:
- Общая бактериология — изучает морфологию, физиологию и биохимию бактерий, а также их наследственность, эволюцию и распространение в природе.
- Медицинская и ветеринарная бактериология — изучают биологию болезнетворных бактерий, методы диагностики и лечения инфекционных заболеваний человека и животных.
- Сельскохозяйственная бактериология — изучает роль бактерий в плодородии и структуре почвы, в питании растений, переработке сельскохозяйственных продуктов (силосование, квашение).
- Промышленная бактериология — изучает процессы образования бактериями спиртов, органических кислот, ферментов, аминокислот, антибиотиков, стимуляторов роста с использованием бактерий[2].
Бактериология как наука развилась благодаря потребности врачей в проверке и применении микробной теории болезней, а также из-за проблем, связанных с порчей продуктов питания. Основными достижениями в бактериологии за последнее столетие являются разработка многих эффективных вакцин и открытие антибиотиков[3].
История

Бактерии впервые обнаружил голландский натуралист Антони ван Левенгук в 1676 году с помощью микроскопа собственной конструкции и опубликовал свои наблюдения в письмах в Королевское общество Лондона[4].
Венский врач Маркус фон Пленциц утверждал, что заразные болезни вызываются мелкими организмами, открытыми Левенгуком. Название «бактерия» было введено позже в 1828 году Христианом Готфридом Эренбергом и происходит от греческого βακτήριον «бактерион», что означает «маленькая палочка»[5].
Также считается основоположником бактериологии немецкий ученый Фердинанд Кон, поскольку он первым классифицировал бактерии на основе их морфологии[6].
%252C_microbiologist_and_chemist_Wellcome_V0026980.jpg)
C середины XIX века начался период активного изучения химического состава, роста и размножения бактерий. Открытие французского химика Луи Пастера, что живые организмы являются причиной брожения, является основой для современной микробной теории болезней и антисептического метода лечения. Вместе с немецким микробиологом Робертом Кохом Пастер был одним из первых, кто придерживался микробной теории болезней. В 1881 году Пастер начал разрабатывать программу профилактики против всех потенциально инфекционных болезней. Он разработал и впервые применил вакцины для животных — против холеры кур и сибирской язвы[7]. Благодаря исследованиям Луи Пастера была окончательна подтверждена важность и введена в широкую практику дезинфекция рук в медицине на основе работ учёных Земмельвейса и Листера, чьи доводы медицинское сообщество долго не признавало[8].
.jpg)
Позже в XIX веке открыли связь микроорганизмов с болезнями, когда итальянский анатом Филиппо Пачини в 1854 году во Флоренции выделил бактерию холеры Vibrio cholerae и установил чёткую связь присутствия бактерии в кишечнике умерших от холеры пациентов с болезнью[9]. Несмотря на это, открытие возбудителя холеры часто приписывают Роберту Коху, который заново открыл его в 1884 году. Кох работал над холерой, сибирской язвой и туберкулёзом. За доказательство микробной теории болезней при исследовании туберкулёза он получил Нобелевскую премию в 1905 году[10]. Он определил критерии, является ли организм причиной заболевания или нет, которые впоследствии получили название Постулаты Коха[11]. Кох и Пастер сыграли большую роль в развитии антисептики в медицинской терапии. В конце XIX века были введены в практику современные методы бактериологической техники с использованием красителей и способа разделения микроорганизмов в посуде с питательной средой[3].
Несмотря на то, что с XIX века уже было известно, что причиной многих заболеваний являются бактерии, вплоть до XX столетия не существовало эффективных антибактериальных методов лечения[12]. В 1910 году немецкий врач Пауль Эрлих разработал первый антибиотик, заменив красители, которые избирательно окрашивали Treponema pallidum, вызывающую сифилис, на избирательно уничтожающие бактерию соединения. Лекарство было на основе мышьяка и получило название сальварсан (от лат. salve — здоровый, и лат. Arsenicum — мышьяк). Исследования доказали действенность препарата Эрлиха, после чего компания Hoechst получила мировой патент на производство сальварсана и гигантский рынок сбыта[13].
Сальварсан, а затем еще более эффективный и менее токсичный неосальварсан стали первыми лекарствами направленного действия[14], и широко применялись в лечении вплоть до начала использования пенициллина в 1940 году. Открытие антибиотика ознаменовало начало эпохи антимикробной терапии с помощью синтетических лекарств[13].
Важный шаг в изучении бактерий был сделан в 1977 году, когда американский микробиолог Карл Вёзе заключил, что археи имеют отдельную линию эволюции от бактерий[15]. Предложенная им трёхдоменная система разделила все клеточные формы жизни на три царства (домена): археи, бактерии и эукариоты[16].
Бактериологические исследования

Бактериологический анализ
Бактериологический анализ ― это процедура выделения микроорганизмов и определение их чувствительности к противомикробным препаратам, которая позволяет найти причину инфекционного заболевания и подобрать необходимую терапию[17].
Метод заключается в посеве исследуемого материала на питательные среды, выделении чистой культуры возбудителя и его идентификации. В целом бактериологический метод исследования — это многоэтапное исследование, длительностью до нескольких суток.
Определение вида возбудителя производят по следующим признакам:
- морфология
- способность окрашиваться различными красителями
- характер роста на искусственных питательных средах
- биохимические свойства (ферментация углеводов и белков).
Окончательную принадлежность выделенной культуры к определенному виду микроорганизмов устанавливают с помощью иммунологических реакций и изучения антигенной структуры возбудителя[17].
Для врача важно знать насколько эффективно проводится антимикробное лечение, поэтому необходимо оценивать динамику изменения качественного и количественного состава в ходе заболевания и терапии. С помощью бактериологического метода диагностики можно определить, каковы последствия инфекционного процесса.
Основными возбудителями инфекционных заболеваний сейчас являются условно-патогенные микроорганизмы, поэтому важно оценить патогенность выделенной микрофлоры[17].
Материалы для бактериологического исследования
Преимущества и недостатки бактериологического исследования
Преимущества бактериологического посева:
• Высокая специфичность метода
• Для исследования в качестве образца подходит любая биологическая жидкость человека
• Определение чувствительности выявленного патогена к тому или иному лекарству позволяет с высокой точностью проводить лечебные назначения препаратов.
Недостатки бактериологического посева:
• Длительность процесса выполнения анализа
• Высокие требования к забору материала и пробоподготовке
• Необходимый уровень квалификации персонала бактериологических лабораторий[19].
См. также
Примечания
- ↑ РАН, Ин-т лингвистич. исследований. Словарь русского языка: в 4-х т. / Под ред. А. П. Евгеньевой. — 4-е изд.. — М.: Полиграфресурсы, 1999.
- ↑ Большая советская энциклопедия: в 30 т. / гл. ред. А. М. Прохоров.. — 3-е изд.. — М.: Советская энциклопедия.
- 1 2 Introduction to Bacteriology // Medical Microbiology / Samuel Baron. — Galveston (TX): University of Texas Medical Branch at Galveston, 1996. — ISBN 978-0-9631172-1-2. Архивировано 28 сентября 2024 года.
- ↑ J. R. Porter. Antony van Leeuwenhoek: tercentenary of his discovery of bacteria // Bacteriological Reviews. — 1976-06. — Т. 40, вып. 2. — С. 260–269. — ISSN 0005-3678. — doi:10.1128/br.40.2.260-269.1976. Архивировано 21 июля 2024 года.
- ↑ bacteria | Etymology of bacteria by etymonline (англ.). www.etymonline.com. Дата обращения: 1 августа 2024. Архивировано 21 июля 2024 года.
- ↑ Ferdinand Julius Cohn (1828-1898): Pioneer of Bacteriology (англ.). Дата обращения: 1 августа 2024. Архивировано 27 июля 2011 года.
- ↑ Сидорчук А.А. История создания вакцин и вакцинации. Часть I. Краткое введение в вакцинологию. Российский ветеринарный журнал (2018). Дата обращения: 1 августа 2024. Архивировано 1 августа 2024 года.
- ↑ ‘Wash your hands’ was once controversial medical advice. web.archive.org (24 февраля 2021). Дата обращения: 1 августа 2024. Архивировано 24 февраля 2021 года.
- ↑ Filippo Pacini. Osservazioni microscopiche e deduzioni patologiche sul cholera asiatico. — Bencini, 1854. — 38 с. Архивировано 1 августа 2024 года.
- ↑ The Nobel Prize in Physiology or Medicine 1905 (амер. англ.). NobelPrize.org. Дата обращения: 1 августа 2024. Архивировано 23 мая 2020 года.
- ↑ Радиационная биология. Радиоэкология. T. 59, номер 4, 2019. www.sciencejournals.ru. Дата обращения: 1 августа 2024. Архивировано 1 августа 2024 года.
- ↑ Alan J. Thurston. Of Blood, Inflammation and Gunshot Wounds: The History of the Control of Sepsis (англ.) // Australian and New Zealand Journal of Surgery. — 2000-12-05. — Vol. 70, iss. 12. — P. 855–861. — ISSN 0004-8682. — doi:10.1046/j.1440-1622.2000.01983.x. Архивировано 7 января 2025 года.
- 1 2 Amt, Auswärtiges. Химическая пуля Пауля Эрлиха: второй век на службе человечеству. germania-online.diplo.de. Дата обращения: 1 августа 2024. Архивировано 1 августа 2024 года.
- ↑ ЭРЛИХ ПАУЛЬ. www.historymed.ru. Дата обращения: 1 августа 2024. Архивировано 1 августа 2024 года.
- ↑ C R Woese, G E Fox. Phylogenetic structure of the prokaryotic domain: the primary kingdoms. // Proceedings of the National Academy of Sciences of the United States of America. — 1977-11. — Т. 74, вып. 11. — С. 5088–5090. — ISSN 0027-8424. Архивировано 21 июля 2024 года.
- ↑ Laura A. Hug, Brett J. Baker, Karthik Anantharaman, Christopher T. Brown, Alexander J. Probst, Cindy J. Castelle, Cristina N. Butterfield, Alex W. Hernsdorf, Yuki Amano, Kotaro Ise, Yohey Suzuki, Natasha Dudek, David A. Relman, Kari M. Finstad, Ronald Amundson, Brian C. Thomas, Jillian F. Banfield. A new view of the tree of life (англ.) // Nature Microbiology. — 2016-04-11. — Vol. 1, iss. 5. — P. 1–6. — ISSN 2058-5276. — doi:10.1038/nmicrobiol.2016.48. Архивировано 21 октября 2019 года.
- 1 2 3 Достоинства бактериологического метода диагностики инфекционных заболеваний. hakmedical.kz. Дата обращения: 1 августа 2024. Архивировано 1 августа 2024 года.
- ↑ А. А. Карамышева , О. Н. Барканова. ЗАБОР МАТЕРИАЛА ДЛЯ БАКТЕРИОЛОГИЧЕСКОГО ИССЛЕДОВАНИЯ КАК ОСНОВА УСПЕХА АНТИБАКТЕРИАЛЬНОЙ ТЕРАПИИ. НУЗ Отделенческая клиническая больница на ст. Волгоград-1 ОАО «РЖД», Кафедра клинической фармакологии и интенсивной терапии с курсами клинической фармакологии ФУВ, клинической аллергологии ФУВ ВолгГМУ. Дата обращения: 1 августа 2024. Архивировано 19 мая 2024 года.
- ↑ А. С. Есаулов, Н. Н. Митрофанова, В. Л. Мельников. Бактериологический метод лабораторной диагностики: учебное пособие. — Пенза: Издательство ПГУ, 2015. — 84 с. — ISBN 978-5-906831-14-9. Архивировано 1 августа 2024 года.
Литература
- Бактериология // Большая советская энциклопедия : [в 30 т.] / гл. ред. А. М. Прохоров. — 3-е изд. — М. : Советская энциклопедия, 1969—1978.
- Бактериологические методики // Большая медицинская энциклопедия : в 30 т. / гл. ред. Б. В. Петровский. — 3-е изд. — М. : Советская энциклопедия, 1975. — Т. 2 : Антибиотики — Беккерель. — 608 с. : ил.
- Бактериологическое исследование // Ветеринарный энциклопедический словарь — М.: Советская энциклопедия, 1981. — 640 с.